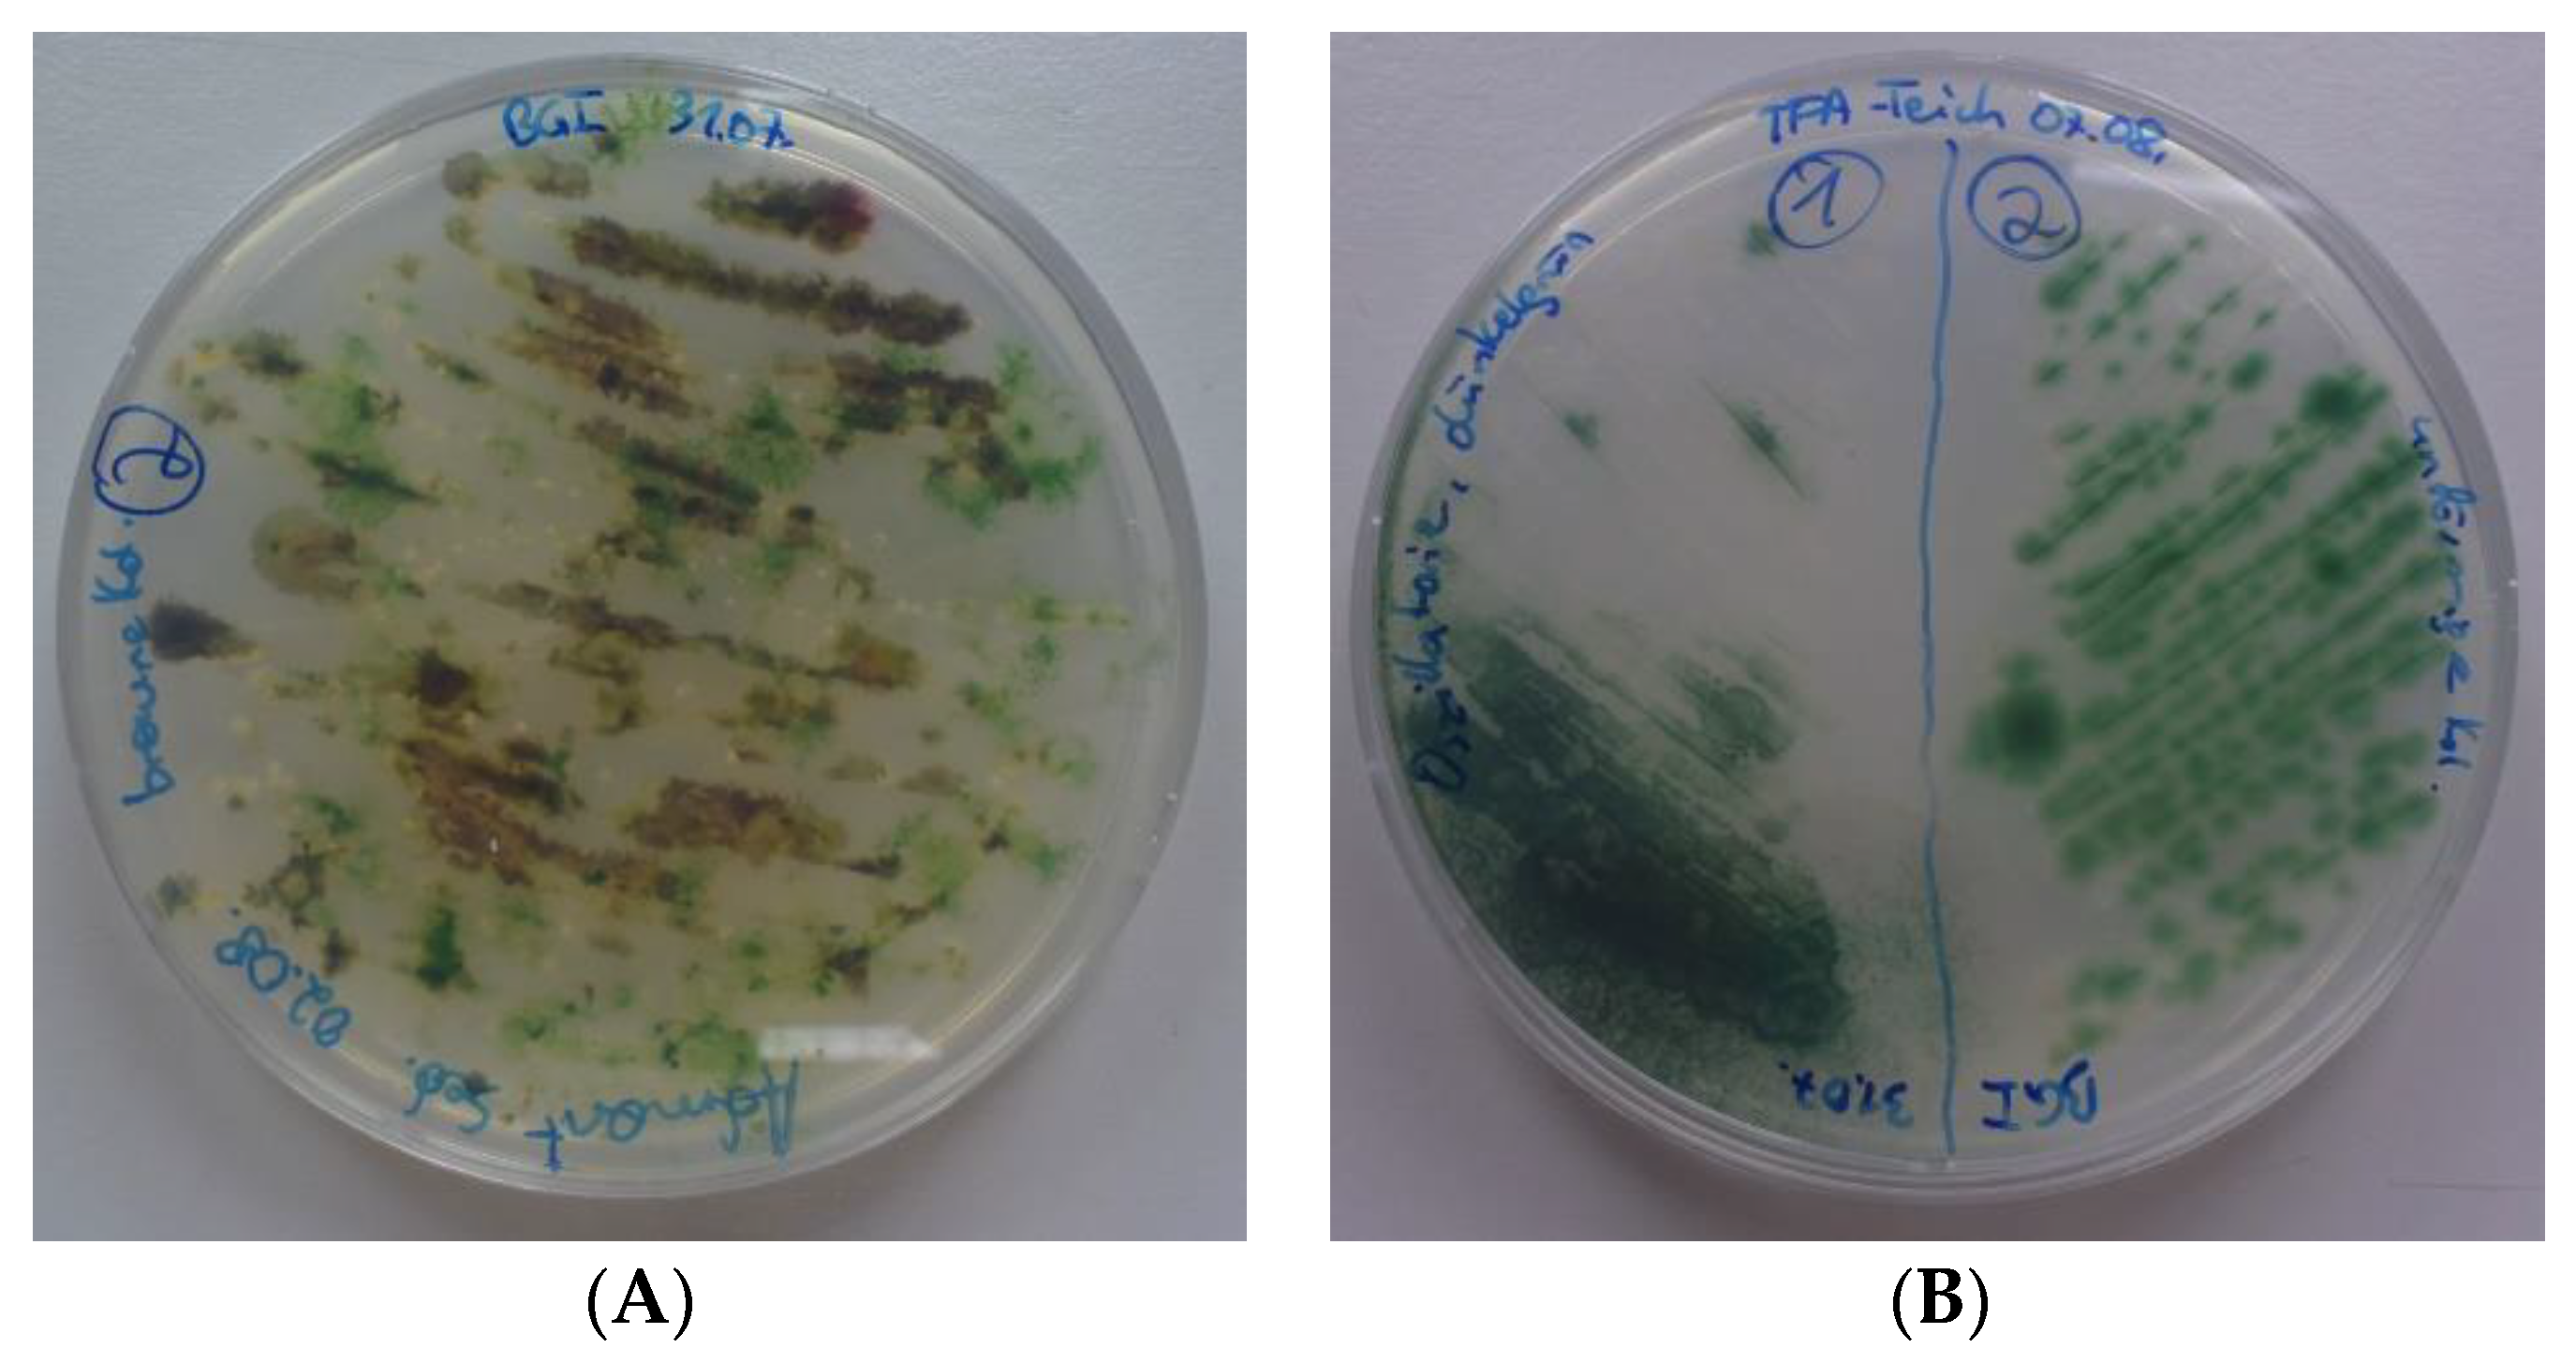
Bioengineering 09 00178 g004 550

Appendix B. Sequences of Cyanobacteria Isolates
>Beninar4
GGCTGGAaCGGTCGCTanCnCccgaTGTGCCGgnnGgTGAAATATTTATAGCCtgtggaTGAGCTTGCGTCTGATTAGCTAGTTGGAGTGGTAACGGCACACCAAGGCGACAATCAGTAACTGGTCTgAGAGGATGACCAGTCACACTGGGaCTGAGAnncGGCccaGACTCCTACGGGAGGCAGCAGTGGGGAATTTTCCGCAATGGGCGAAAGCCTGACGGAGCAATACCGCGTGAGGGATGAAGGTTCGTGGATTGTAAACCTCTTTTTTCAGGGAAGaTAATGACGGTACCTGAAGAATAAGCATCGGCTAACTCCGTGCCAGCAGCCGCGGTAAGACGGAGgaTGCAAGCGTTATCCGGAATTATTGGGCGTAAAGCGTACGCAGGTGGCCCATCAAGTCTATTGTCAAagAGCAGAGCTCAACTCTGTAAAGGCGATAGAAACTGGTGAGCTAGAGTATGGTAGGGGCAGGAGGAATTCCCAGTGTAGCGGTGAAATGCGTAGATATTGGGAAGAACACCagtGGCGAAAgCGTCCTGCCAaGCCAAAACTGaCACTCATGTAcgAAAgCTAGGggagnAAaagggaTTAnntACCCcAGTAGTCAa
>Greifenstein1
gcGtcagTTGagnnCcAGCAGgacGCTTtCGCCACTggtGTTCTTCCAGATATCTACGCATTTCACCGCTACACCTGGAATTCCTCCTGCCCCTATCTCTCTCTAGTCTCACAGTTTCCATTGCCGATCCAAGGTTGAGCCTCGGGCTTTGACAACAGACTTATCAAACAGCCTACGTACGCTTTACGCCCAATAATTCCGGATAACGCTTGCATCCTCCGTCTTACCGCGGCTGCTGGCACGGAGTTAGCCGATGCTTATTCGTTAGGTACCGTCATTATCTTCCCTAACAAAAGAGGTTTACAACCCACAGGCCTTCGTCCCTCACGCGGTATTGCTCCGTCAGGCTTTCGCCCATTGCGGAAAATTCCCCACTGCTGCCTCCCGTAGGAGTCTGGGCCGTGTCTCAGTCCCAGTGTGACTGGTCATCCTCTCAGACCAGTTATCGATCGTCGCCATGGTAGGCCGTTACCCCACCATCTAGCTAATCGAACGCAAGCTCATCTACAGGCATTAAAACTTTCACCCGAAGGCATATCCGGTATTAGCAGTCATTTCTAACTGTTGTCCCGAACCTATAGGTAGATTCTTACGCGTTancaaCCcngTCCGa
>Greifenstein2
cngcGtcagTTGAgaTCcAGCAGGacGCTTtCGCCACTGgtGTTCTTCCAGATATCTACGCATTTCACCGCTACACCTGGAATTCCTCCTGCCCCTATCTCTCTCTAGTCTCACAGTTTCCATTGCCTTTACAAGGTTGAGCCTCGCGCTTTGACAACAGACTTATCAAACAGCCTACGTACGCTTTACGCCCAATAATTCCGGATAACGCTTGCATCCTCCGTCTTACCGCGGCTGCTGGCACGGAGTTAGCCGATGCTTATTCGTTAGGTACCGTCATTATCTTCCCTAACAAAAGAGGTTTACAATCCACAGACCTTCGTCCCTCACGCGGTATTGCTCCGTCAGGCTTTCGCCCATTGCGGAAAATTCCCCACTGCTGCCTCCCGTAGGAGTCTGGGCCGTGTCTCAGTCCCAGTGTGACTGGTCATCCTCTCAGACCAGTTATCGATCGTCGCCATGGTAGGCCGTTACCCCACCATCTAGCTAATCGAACGCAAGCTCATCTACAGGCATTAAAACTTTCACCCGAAGGCACATCCGGTATTAGCAGTCATTTCTAACTGTTGTCCCGAACCTATAGGTAGATTCTTAcncGTTancaaCCCcGTCCGa
>Grönland3
tgnnCGTcaGTTatGGCCcAGCAGAGCGCCTTCGCCACTggtGTTCTTCCCGATATCTACGCATTTCACCGCTACACCGGGAATTCCCTCTGCCCCTACCACACTCAAGCCTTGTAGTTTCCATCGCTGAAATGGAGTTAAGCTCCACGCTTTAACGACAGACTTACAAGGCCGCCTGCGGACGCTTTACGCCCAATAATTCCGGATAACGCTTGCCACTCCCGTATTACCGCGGCTGCTGGCACGGAATTAGCCGTGGCTTATTCCTCAAGTACCGTCATGTCTTCTTCCTTGAGAAAAGAGGTTTACAGCCCAGAGGCCTTCATCCCTCACGCGGCGTTGCTCCGTCAGGCTTTCGCCCATTGCGGAAAATTCCCCACTGCTGCCTCCCGTAGGAGTCTGGGCCGTGTCTCAGTCCCAGTGTGGCTGATCATCCTCTCAGACCAGCTACTGATCGTCGCCTTGGTGGGCCATTACCCCACCAACTAGCTAATCAGACGCGGGCTCATCCTCAGGCGAAATTCATTTCACCTCTCGGCATATGGGGTATTAGCGGCCGTTTCCGGCCGTTATCCCCCTCCTGAGGGCAAaTTCCCAcgcGTTanc
>großeTulln1
ttnagCGtCaGTTGagatCCAGCAGgaCGCTTtCGCCACTggtGTTCTTCCAGATATCTACGCATTTCACCGCTACACCTGGAATTCCTCCTGCCCCTATCTCTCTCTAGTCTCACAGTTTCCATTGCCGATCCAAGGTTGAGCCTCGGGCTTTGACAACAGACTTATCAAACAGCCTACGTACGCTTTACGCCCAATAATTCCGGATAACGCTTGCATCCTCCGTCTTACCGCGGCTGCTGGCACGGAGTTAGCCGATGCTTATTCGTTAGGTACCGTCATTATCTTCCCTAACAAAAGAGGTTTACAACCCACAGGCCTTCGTCCCTCACGCGGTATTGCTCCGTCAGGCTTTCGCCCATTGCGGAAAATTCCCCACTGCTGCCTCCCGTAGGAGTCTGGGCCGTGTCTCAGTCCCAGTGTGACTGGTCATCCTCTCAGACCAGTTATCGATCGTCGCCATGGTAGGCCATTACCCCACCATCTAGCTAATCGAACGCAAGCTCATCTACAGGCATTAAAACTTTCACCCGAAGGCATATCCGGTATTAGCAGTCATTTCTAACTGTTGTCCCGAACCTATAGGTAGATTCTTACGCGttc
>großeTulln3
gtcngTtGAGatccnGCAGGAcGcnTTTcnGCcACTGGTGTtcnTTCCnAGATATCTACGCATTTCACCGCTACACCTGgAaTTCCTCCTGCCCCTATCTCTCTCTAGTCTCACAGTTTCCATTGCCGATCCAAGGTTGAGCCTCGGGCTTTGACAACAGACTTATCAAACAGCCTACGTACGCTTTACGCCCAATAATTCCGGATAACGCTTGCATCCTCCGTCTTACCGCGGCTGCTGGCACGGAGTTAGCCGATGCTTATTCGTTAGGTACCGTCATTATCTTCCCTAACAAAAGAGGTTTACAACCCACAGGCCTTCGTCCCTCACGCGGTATtGCTCCGTCAGGCTTTCGCCCATTGCGGAAAATTCCCCACTGCTGCCTCCCGTAGGAGTCTGGGCCGTGTCTCAGTCCCAGTGTGACTGGTCATCCTCTCAGACCAGTTATCGATCGTCGCCATGGTAGGCCATTACCCCACCATCTAGCTAATCGAACGCAAGCTCATCTACAGGCATTAAAACTTTCACCCGAAGGCATATCCGGTATTAGCAGTCATTTCTAACTGTTGTCCCGAACCTATAGGTAGATTCTTACGCGTta
>IFATeich1
anTTGCGGCCTAGCAGAGCGCTTtCGCCACCGgtgTTCTTCCTGATCTCTACGCATTTCACCGCTACACCAGGAATTCCCTCTGCCCCGAACGCACTCTAGTCTTGTAGTTTCCACTGCCCTTATGCGGTTAAGCCGCACGCTTTAACAATAGACTTACAAAACCACCTGCGGACGCTTTACGCCCAATCATTCCGGATAACGCTTGCATCCTCCGTATTACCGCGGCTGCTGGCACGGAGTTAGCCGATGCTTATTCCTCAGGTACCGTCATCATCTTCCCTGAGAAAAGAGGTTTACAACCCAAGAGCCTTCCTCCCTCACGCGGTATTGCTCCGTCAGGCTTTCGCCCATTGCGGAAAATTCCCCACTGCTGCCTCCCGTAGGAGTCTGGACCGTGTCTCAGTTCCAGTGTGGCTGATCATCCTCTCAGACCAGCTACTGATCGCAGCCTTGGTAGTCCATTACACCACCAACTAGCTAATCAGACGCGAGCTCATCTCTTGGCAATTAATCTTTCACCCGTAGGCACATCCGGTATTAGCAGCCGTTTCCAACTGTTGTCCCGAACCAAAAGGCAGATTCTCACGCGTta
>IFATeich3
CCtcagtGtcagTTtcaGCCCAGTAGCACGCTTtCGCCACCGATGTTCTTCCCAATATCTACGCATTTCACCGCTACACTGGGAATTCCTGCTACCCCTACTGTACTCTAGTCTTGCAGTTTCCACCGCTCTTATGGAGTTAAGCTCCATTCTTTAACAGCAGACTTGCAAAACCACCTACGGACGCTTTACGCCCAATAATTCCGGATAACGCTTGCATCCTCCGTATTACCGCGGCTGCTGGCACGGAGTTAGCCGATGCTTATTCATCAGGTACCGTCATTTTTTTCTTCCCTGATAAAAGAGGTTTACAATCCAAGGACCTTCCTCCCTCACGCGGTATTGCTCCGTCAGGCTTTCGCCCATTGCGGAAAATTCCCCACTGCTGCCTCCCGTAGGAGTCTGGGCCGTGTCTCAGTCCCAGTGTGGCTGCTCATCCTCTCAGACCAGCTACTGATCGTTGCCATGGTAGGCTCTTACCCCACCATCTAGCTAATCAGACGCGAGCCCATCTTCAGACGATAAATCTTTCACCTTTCGGCACATTGGGTATTAGCAGTCGTTTCCAACTGTTGTCCCCATTCTGAAGGCAGGTTCTCACGCG
>IFATeich4
ttCngcGTcagTTGAGATCCAGCAGGACGCTTtCGCCACTggtGTTCTTCCAGATATCTACGCATTTCACCGCTACACCTGGAATTCCTCCTGCCCCTATCTCTCTCTAGTCTCACAGTTTCCATTGCCGATCCAAGGTTGAGCCTCGGGCTTTGACAACAGACTTATGAAACAGCCTACGTACGCTTTACGCCCAATAATTCCGGATAACGCTTGCATCCTCCGTCTTACCGCGGCTGCTGGCACGGAGTTAGCCGATGCTTATTCGTTAGGTACCGTCATTATCTTCCCTAACAAAAGAGGTTTACAACCCACAGGCCTTCGTCCCTCACGCGGTATtgCTCCGTCAGGCTTTCGCCCATTGCGGAAAATTCCCCACTGCTGCCTCCCGTAGGAGTCTGGGCCGTGTCTCAGTCCCAGTGTGACTGGTCATCCTCTCAGACCAGTTATCGATCGTCGCCATGGTAGGCCGTTACCCCACCATCTAGCTAATCGAACGCAAGCTCATCTACAGGCATTAAAACTTTCACCCGAGGGCATATCCGGTATTAGCAGTCATTTCTAACTGTTGTCCCGAACCTATAGGTAGATTCTTACGCGtt
>Steg2
aCGGCCGgAaCGGCCGCTAaTACCCcATATGCCGagaGGTGAAATGAATTTCGCCTgaggatGAGCCCGCGTCTGATTAGCTAGTTGGTGGGGTAATGGCCCACCAAGGCGACGATCAGTAGCTGGTCTGAGAGGATGATCAGCCACACTGGGACTGAGACACGGCCCAGACTCCTACGGGAGGCAGCAGTGGGGAATTTTCCGCAATGGGCGAAAGCCTGACGGAGCAACGCCGCGTGAGGGATGAAGGCCTCTGGGCTGTAAACCTCTTTTCTCAAGGAAGAAGACATGACGGTACTTGAGGAATAAGCCACGGCTAATTCCGTGCCAGCAGCCGCGGTAATACGGGAGTGGCAAGCGTTATCCGGAATTATTGGGCGTAAAGCGTCCGCAGGCGGCCTTGTAAGTCTGTCGTTAAAGCGTGGAGCTTAACTCCATTTGAGCGATGGAAACTACAAGGCTTGAGTGTGGTAGGGGCAGAGGGAATTCCCGGTGTAGCGGTGAAATGCGTAGATATCGGGAAGAACACCAGTGGCGAAGGCGCTCTGCTGGGCCATAACTGACGCTCATGGACGAAAGCCAGGGGAGcnAAaGGGATTAGATACCCCtGTAgtaaa
>Steg1
ttncgcAAtggGCGAAAGCCTGACGGAGCAACGCCGCGTGAGGGATGAAGGCCTCTGGGCTGTAAACCTCTTTTCTCAAGGAAGAAGACATGACGGTACTTGAGGAATAAGCCACGGCTAATTCCGTGCCAGCAGCCGCGGTAATACGGGAGTGGCAAGCGTTATCCGGAATTATTGGGCGTAAAGCGTCCGCAGGCGGCCTTGTAAGTCTGTCGTTAAAGCGTGGAGCTTAACTCCATTTGAGCGATGGAAACTACAAGGCTTGAGTGTGGTAGGGGCAGAGGGAATTCCCGGTGTAGCGGTGAAATGCGTAGATATCGGGAAGAACACCAGTGGCGAAGGCGCTCTGntnGGCCAtaActgaCg
>Admont5
cngcGTcagTtgagaTCCAGCAGgncgCTTTCGCCACTggtGTTCTTCCAGATATCTACGCATTTCACCGCTACACCTggAaTTCCTCCTGCCCCTATCTCTCTCTAGTCTCACAGTTTCCATTGCCGATCCAAGGTTGAGCCTCGGGCTTTGACAACAGACTTATCAAACAGCCTACGTACGCTTTACGCCCAATAATTCCGGATAACGCTTGCATCCTCCGTCTTACCGCGGCTGCTGGCACGGAGTTAGCCGATGCTTATTCGTTAGGTACCGTCATTATCTTCCCTAACAAAAGAGGTTTACAACCCACAGGCCTTCGTCCCTCACGCGGTATTGCTCCGTCAGGCTTTCGCCCATTGCGGAAAATTCCCCACTGCTGCCTCCCGTAGGAGTCTGGGCCGTGTCTCAGTCCCAGTGTGACTGGTCATCCTCTCAGACCAGTTATCGATCGTCGCCATGGTAGGCCATTACCCCACCATCTAGCTAATCGAACGCAAGCTCATCTACAGGCATTAAAACTTTCACCCGAAGGCATATCCGGTATTAGCAGTCATTTCTAACTGTTGTCCCGAACCTATAGGTAGATTCTTACGCGTTACTCACCCGTCCGa
>grosseTulln2
CGTcagTTATGGCCcaGCAGAGCGCCTTCGCCACTGGTGTTCTTCCCGATATCTACGCATTTCACCGCTACACCGGGAATTCCCTCTGCCCCTACCACACTCAAGCCTTGTAGTTTCCATCGCTGAAATGGAGTTAAGCTCCACGCTTTAACGACAGACTTACAAGGCCGCCTGCGGACGCTTTACGCCCAATAATTCCGGATAACGCTTGCCACTCCCGTATTACCGCGGCTGCTGGCACGGAATTAGCCGTGGCTTATTCCTCAAGTACCGTCATGTCTTCTTCCTTGAGAAAAGAGGTTTACAGCCCAGAGGCCTTCATCCCTCACGCGGCGTTGCTCCGTCAGGCTTTCGCCCATTGCGGAAAATTCCCCACTGCTGCCTCCCGTAGGAGTCTGGGCCGTGTCTCAGTCCCAGTGTGGCTGATCATCCTCTCAGACCAGCTACTGATCGTCGCCTTGGTGGGCCATTACCCCACCAACTAGCTAATCAGACGCGGGCTCATCCTCAGGCGAAATTCATTTCACCTCTCGGCATATGGGGTATTAGCGGCCGTTTCCGGCCGTTATCCCCCTCCTGAGGGCAGATTcnnACGCGTTACTCACCCGTCCGGa
>Branna1
agngTcnGTTacGgCCTAGCAgagCGCCTTCGCCACCggtgTTCTTCCtgaTCTCTACGCATTTCACCGCTACACCAGGAaTTCCCTCTGCCCCGAACGTACTCTAGCTGTGTAGTTTCCACTGCTTTTATGAGGTTAAGCCTCACTCTTTAACAGCAGACTTACATTGCCACCTGCGGACGCTTTACGCCCAATCATTCCGGATAACGCTTGCATCCTCCGTATTACCGCGGCTGCTGGCACGGAGTTAGCCGATGCTTATTCCTCAAGTACCTTCAGTTCTTATTCCTTGAGAAAAGAGGTTTACAACCCAAGAGCCTTCCTCCCTCACGCGGTATTGCTCCGTCAGGCTTTCGCCCATTGCGGAAAATTCCCCACTGCTGCCTCCCGTAGGAGTCTGGGCCGTGTCTCAGTCCCAGTGTGGCTGATCATCCTCTCAGACCAGCTACTGATCGTCGCCTAGGTGCGCTCTTACCACACCTACTAGCTAATCAGACGCGAGCTCATCTTCAGGCAGTTAACCTTTCACCTTTCGGCACATCCGGTATTAGCCACCGTTTCCAGTGGTTGTCCCCGACCTCAAGCTAGannnTCACgnnTTACTCACCCGTCCGgaga
>Branna2
tnGtCCtnagTGtcagTTaCGGCCTAGCAGAGCGCCTTCGCCACCGGTGTTCTTCCTGATCTCTACGCATTTCACCGCTACACCAGGAATTCCCTCTGCCCCGAACGTACTCTAGCTGTGTAGTTTCCACTGCTTTTATGAGGTTAAGCCTCACTCTTTAACAGCAGACTTACATTGCCACCTGCGGACGCTTTACGCCCAATCATTCCGGATAACGCTTGCATCCTCCGTATTACCGCGGCTGCTGGCACGGAGTTAGCCGATGCTTATTCCTCAAGTACCTTCAGTTCTTATTCCTTGAGAAAAGAGGTTTACAACCCAAGAGCCTTCCTCCCTCACGCGGTATTGCTCCGTCAGGCTTTCGCCCATTGCGGAAAATTCCCCACTGCTGCCTCCCGTAGGAGTCTGGGCCGTGTCTCAGTCCCAGTGTGGCTGATCATCCTCTCAGACCAGCTACTGATCGTCGCCTAGGTGCGCTCTTACCACACCTACTAGCTAATCAGACGCGAGCTCATCTTCAGGCAGTTAACCTTTCACCTTTCGGCACATCCGGTATTAGCCACCGTTTCCAGTGGTTGTCCCCGACCTCAAGCTAGATTCTCAcGCGTTnccaaCCcgtCCGa
>Branna3
annGTcaGTTacGGCCTAGCAGAgCGCCTTCGCCACCGGTGTTCTTCCTGATCTCTACGCATTTCACCGCTACACCAGGAATTCCCTCTGCCCCGAACGTACTCTAGCTGTGTAGTTTCCACTGCTTTTATGAGGTTAAGCCTCACTCTTTAACAGCAGACTTACATTGCCACCTGCGGACGCTTTACGCCCAATCATTCCGGATAACGCTTGCATCCTCCGTATTACCGCGGCTGCTGGCACGGAGTTAGCCGATGCTTATTCCTCAAGTACCTTCAGTTCTTATTCCTTGAGAAAAGAGGTTTACAACCCAAGAGCCTTCCTCCCTCACGCGGTATTGCTCCGTCAGGCTTTCGCCCATTGCGGAAAATTCCCCACTGCTGCCTCCCGTAGGAGTCTGGGCCGTGTCTCAGTCCCAGTGTGGCTGATCATCCTCTCAGACCAGCTACTGATCGTCGCCTAGGTGCGCTCTTACCACACCTACTAGCTAATCAGACGCGAGCTCATCTTCAGGCAGTTAACCTTTCACCTTTCGGCACATCCGGTATTAGCCACCGTTTCCAGTGGTTGTCCCCGACCTCAAGCTAgannnnncnCGCGTTACTnaaCCCGTCCG
>Branna4
GTcnGTTAcGGCCTAGCAGAGCGCCTTCGCCACCGGTGTTCTTCCtgaTCTCTACGCATTTCACCGCTACACCAggAaTTCCCTCTGCCCCGAACGTACTCTAGCTGTGTAGTTTCCACTGCTTTTATGAGGTTAAGCCTCACTCTTTAACAGCAGACTTACATTGCCACCTGCGGACGCTTTACGCCCAATCATTCCGGATAACGCTTGCATCCTCCGTATTACCGCGGCTGCTGGCACGGAGTTAGCCGATGCTTATTCCTCAAGTACCTTCAGTTCTTATTCCTTGAGAAAAGAGGTTTACAACCCAAGAGCCTTCCTCCCTCACGCGGTATTGCTCCGTCAGGCTTTCGCCCATTGCGGAAAATTCCCCACTGCTGCCTCCCGTAGGAGTCTGGGCCGTGTCTCAGTCCCAGTGTGGCTGATCATCCTCTCAGACCAGCTACTGATCGTCGCCTAGGTGCGCTCTTACCACACCTACTAGCTAATCAGACGCGAGCTCATCTTCAGGCAGTTAACCTTTCACCTTTCGGCACATCCGGTATTAGCCACCGTTTCCAGTGGTTGTCCCCGACCTCAAGCTAGaTtnncACGCGTTacccaCCCGTCCGa
>Branna5
cagtGtcagTTGCGGCCTAGCAGAGCGCTTtCGCCACCGgtGTTCTTCCTGATCTCTACGCATTTCACCGCTACACCAGGAATTCCCTCTGCCCCGAACGCACTCTAGTCTTGTAGTTTCCACTGCCCTTATGCGGTTAAGCCGCACGCTTTAACAATAGACTTACAAAACCACCTGCGGACGCTTTACGCCCAATCATTCCGGATAACGCTTGCATCCTCCGTATTACCGCGGCTGCTGGCACGGAGTTAGCCGATGCTTATTCCTCAGGTACCGTCATCATCTTCCCTGAGAAAAGAGGTTTACAACCCAAGAGCCTTCCTCCCTCACGCGGTATTGCTCCGTCAGGCTTTCGCCCATTGCGGAAAATTCCCCACTGCTGCCTCCCGTAGGAGTCTGGACCGTGTCTCAGTTCCAGTGTGGCTGATCATCCTCTCAGACCAGCTACTGATCGCAGCCTTGGTAGTCCATTACACCACCAACTAGCTAATCAGACGCGAGCTCATCTCTTGGCAATTAATCTTTCACCCGTAGGCACATCCGGTATTAGCAGCCGTTTCCAACTGTTGTCCCGAACCAAAAGGCAGannntCACgngTTACtcACCCGTCcgg
>Branna6
agcgtcngTTGagatCCAGCAggacgCTTTCGCCACTggtgTTCTTCCAGATATCTACGCATTTCACCGCTACACCTGGAATTCCTCCTGCCCCTATCTCTCTCTAGTCTCACAGTTTCCATTGCCTTTCCAAGGTTGAGCCTCGGGCTTTGACAACAGACTTATAAAACAGCCTACGTACGCTTTACGCCCAATAATTCCGGATAACGCTTGCATCCTCCGTCTTACCGCGGCTGCTGGCACGGAGTTAGCCGATGCTTATTCGTTAGGTACCGTCATTATCTTCCCTAACAAAAGAGGTTTACAATCCACAGACCTTCGTCCCTCACGCGGTATTGCTCCGTCAGGCTTTCGCCCATTGCGGAAAATTCCCCACTGCTGCCTCCCGTAGGAGTCTGGACCGTGTCTCAGTTCCAGTGTGACTGGTCATCCTCTCAGACCAGTTACCGATCGTCGCCATGGTGTGCCGTTACCACTCCATCTAGCTAATCGGACGCAAGCTCATCTACAGGCATTTAAACTTTCACCCGAAGGCACATCCGGTATTAGCAGTCATTTCTAACTGTTGTCCCGAACCTATAGGTAGATTCTTACGcnTtacna
>Heinrichs1
agnGtcagTTcaGGCCcAGTAGAGCGCTTtCGCCACTGGTGTTCTTCCAGATATCTACGCATTTCACCGCTACACCTGGAATTCCCTCTACCCCTACCGAACTCTAGTCTCTCAGTTTCCACTCCCTTTACAAGGTTAAGCCTCGCGCTTTGAAAGCAGACTTGATAAACCACCTGCGGACGCTTTACGCCCAATAATTCCGGATAACGCTTGCATCCTCCGTCTTACCGCGGCTGCTGGCACGGAGTTAGCCGATGCTTATTCCTCAGGTACCGTCAGGTTTCTTCCCTGAGAAAAGAGGTTTACGACCCAAGAGCCTTCTTCCCTCACGCGGTATTGCTCCGTCAGGCTTTCGCCCATTGCGGAAAATTCCCCACTGCTGCCTCCCGTAGGAGTCTGGGCCGTGTCTCAGTCCCAGTGTGGCTGATCATCCTCTCAGACCAGCTACTGATCATTGCCTTGGTCGGCCTTTACCCAACCAACTAGCTAATCAGACGCGAGCACTTCCCTTGGCAATAAATCTTTCACCTTTCGGCACATTCGGTATTAGCAGTCGTTTCCAACTGTTGTCCCGAACCAAGGGGCGGTTTCTCACGCGTTaccaaCCCGTCCGaana
>Heinrichs3
agtGTcnGTaTnGTCCTAGCAGAGCGCTTtCGCCACCGGTGTTCTTCCCAATCTCTACGCATTTCACCGCTACACTGGGAATTCCCTCTACCCCTAACATACTCTAGTCTTATAGTTTCCACTGCCTGTATGTGGTTGAGCCACACGCTTTAACAGCAGACTTACAAAACCACCTGCGGACGCTTTACGCCCAATCATTCCGGATAACGCTTGCATCCTCTGTATTACCGCGGCTGCTGGCACAGAGTTAGCCGATGCTTATTCCTCAAGTACCGTCatnATCTTCCTTGAGAAAAGAGGTTTACGACCCAAAAGCCTTCGTCCCTCACGCGGTATTGCTCCGTCAGGCTTTCGCCCATTGCGGAAAATTCCCCACTGCTGCCTCCCGTAGGAGTCTGGACCGTGTCTCAGTTCCAGTGTGGCTGATCGTCCTCTCAGACCAGCTACAGATCGATGCCTAGGTAGTCTCTTACACCACCTACTAGCTAATCTGACGCGAGCTCAaTtnCAGGCAATTAATCTTTCACCTTTCGGCACATCCGGTATTAGCAGTCATTTCTAACTGTTGTCCCCGACCTGAAGanaGATTCTCACGCGTTaccaaCCCGTCCGa
>Heinrichs4
gnCCtnagtgtcagTTGCAGCCTAGCAGGgCGCTTTCGCCACCggtgTTCTTCCTGATCTCTACGCATTTCACCGCTACACCAGgAaTTCCCCCTGCCCCGAATGCACTCTAGTTACACAGTTTCCACTGCCTTTATGCGGTTGAGCCGCACGCTTTGACAATAGACTTGCATCACCACCTACGGACGCTTTACGCCCAATCATTCCGGATAACGCTTGCATCCTCCGTATTACCGCGGCTGCTGGCACGGAGTTAGCCGATGCTTCTTCCTCAGGTACCGTCATCTCTTCTTCCCTGAGAAAAGAGGTTTACAACCCAAGAGCCTTCCTCCCTCACGCGGTATTGCTCCGTCAGGCTTTCGCCCATTGCGGAAAATTCCCCACTGCTGCCTCCCGTAGGAGTCTGGGCCGTGTCTCAGTCCCAGTGTGGCTGATCATCCTCTCAGACCAGCTACTGATCGTCGCCATGGTAGGCTCTTACCCCACCATCTAGCTAATCAGACGCGAGCTCATCTCTAGGCAGCTAGCCTTTCACCTCTTCGGCACATCCGGTATTAGCCACCGTTTCCAGTGGTTGTCCCGAACCTAGAGCCAGATTCTCACGCGTTACTcaCCCGTCCGa
>Heinrichs6
gTcaGTnnTAGCCcAGTAGAGTGCCTTCGCCATCGGTGTTCTTTCCAATATCTACGCATTTCACCGCTCCACTGgAAaTTCCCTCTACCCCTACTATACTCAAgTTtCCCAGTTTCCAATGCTGAATTGAGGTTGAGCCTCAAGGTTTAACAGTGGACTTAAGAAACCACCTGCAGACGCTTTACGCCCAGTAATTCCGGATAACACTTGCATCCTCCGTCTTACCGCGGCTGCTGGCACGGaGTTAGCCGATGCTTCGTCTCCTAAGTAACGTCAGATCTTCCTCCTTAGGTAACAGAGGTTTACAACTCAGTAAGCCTTCTTCCCTCACGCGGTATTGCTCTGTCAGGCTTTCGCCCATTGCAGaaaaTTCCTCACTGCTGCCtCCcGTAGGAGTCTGGACCGTGTCTCAGTTCCAGTGTGGCTGATCGTCCTCTCAGACCAGCTACTGATCGTCGCCTTGGTAGGCCTTTACCCCACCAACTAGCTAATCAGCCGCGAGCTTCTCTTTAGGCAGATTTCTCTGTTTGACCCGAAGGCATATGGAGTTTTAGCAGGTGTTTCCCCCTGTTATCCTCCTCCTAAAGnnnAaTTCTCACGCGTTacnaaCc
>Mondteich1
agtGTcaGTaTtGTCCTAGCAGAGCGCTTtCGCCACCggtGTTCTTCCCAATCTCTACGCATTTCACCGCTACACTGGGAATTCCCTCTACCCCTAACATACTCTAGTCTTATAGTTTCCACTGCCTGTATGTGGTTGAGCCACACGCTTTAACAGCAGACTTACAAAACCACCTGCGGACGCTTTACGCCCAATCATTCCGGATAACGCTTGCATCCTCTGTATTACCGCGGCTGCTGGCACAGAGTTAGCCGATGCTTATTCCTCAAGTACCGTCatnATCTTCCTTGAGAAAAGAGGTTTACGACCCAAAAGCCTTCGTCCCTCACGCGGTATTGCTCCGTCAGGCTTTCGCCCATTGCGGAAAATTCCCCACTGCTGCCTCCCGTAGGAGTCTGGACCGTGTCTCAGTTCCAGTGTGGCTGATCGTCCTCTCAGACCAGCTACAGATCGATGCCTAGGTAGTCTCTTACACCACCTACTAGCTAATCTGACGCGAGCTCAaTtnCAGGCAATtAATCTTTCACCTTTCGGCACATCCGGTATTAGCAGTCATTTCTAACTGTTGTCCCCGACCTGAAGataGATTCTCACGCGTTncna
>Mondteich2
cagngTcnGTaTtGTCCTAGCAGAGCGCTTtCGCCACCGgtGTTCTTCCCAATCTCTACGCATTTCACCGCTACACTGGGAATTCCCTCTACCCCTAACATACTCTAGTCTTATAGTTTCCACTGCCTGTATGTGGTTGAGCCACACGCTTTAACAGCAGACTTACAAAACCACCTGCGGACGCTTTACGCCCAATCATTCCGGATAACGCTTGCATCCTCTGTATTACCGCGGCTGCTGGCACAGAGTTAGCCGATGCTTATTCCTCAAGTACCGTCatnATCTTCCTTGAGAAAAGAGGTTTACGACCCAAAAGCCTTCGTCCCTCACGCGGTATTGCTCCGTCAGGCTTTCGCCCATTGCGGAAAATTCCCCACTGCTGCCTCCCGTAGGAGTCTGGACCGTGTCTCAGTTCCAGTGTGGCTGATCGTCCTCTCAGACCAGCTACAGATCGATGCCTAGGTAGTCTCTTACACCACCTACTAGCTAATCTGACGCGAGCTCAaTtnCAGGCAATTAATCTTTCACCTTTCGGCACATCCGGTATTAGCAGTCATTTCTAACTGTTGTCCCCGACCTGAAGanaGATTCTCACGCGTTatcaaCCcgTCCGangaa
>Pyhrabruck1
cagnGTcnGTaTtGTCCTAGCAGAGCGCTTtCGCCACCGgTGTTCTTCCCAATCTCTACGCATTTCACCGCTACACTGGGAATTCCCTCTACCCCTAACATACTCTAGTCTTATAGTTTCCACTGCCTGTATGTGGTTGAGCCACACGCTTTAACAGCAGACTTACAAAACCACCTGCGGACGCTTTACGCCCAATCATTCCGGATAACGCTTGCATCCTCTGTATTACCGCGGCTGCTGGCACAGAGTTAGCCGATGCTTATTCCTCAAGTACCGTCatnATCTTCCTTGAGAAAAGAGGTTTACGACCCAAAAGCCTTCGTCCCTCACGCGGTATTGCTCCGTCAGGCTTTCGCCCATTGCGGAAAATTCCCCACTGCTGCCTCCCGTAGGAGTCTGGACCGTGTCTCAGTTCCAGTGTGGCTGATCGTCCTCTCAGACCAGCTACAGATCGATGCCTAGGTAGTCTCTTACACCACCTACTAGCTAATCTGACGCGAGCTCAaTtnCAGGCAATtAATCTTTCACCTTTCGGCACATCCGGTATTAGCAGTCATTTCTAACTGTTGTCCCCGACCTGAAGacaGATTca
>Pyhrabruck2
gCGTcaGTTGAGnTCnAGCAGgacGCTTTCGCCACTGGTGTTCTTCCAGATATCTACGCATTTCACCGCTACACCTGGAATTCCTCCTGCCCCTATCTCTCTCTAGTCTCACAGTTTCCATTGCCGATCCAAGGTTGAGCCTCGGGCTTTGACAACAGACTTATCAAACAGCCTACGTACGCTTTACGCCCAATAATTCCGGATAACGCTTGCATCCTCCGTCTTACCGCGGCTGCTGGCACGGAGTTAGCCGATGCTTATTCGTTAGGTACCGTCATTATCTTCCCTAACAAAAGAGGTTTACAACCCACAGGCCTTCGTCCCTCACGCGGTATTGCTCCGTCAGGCTTTCGCCCATTGCGGAAAATTCCCCACTGCTGCCTCCCGTAGGAGTCTGGGCCGTGTCTCAGTCCCAGTGTGACTGGTCATCCTCTCAGACCAGTTATCGATCGTCGCCATGGTAGGCCATTACCCCACCATCTAGCTAATCGAACGCAAGCTCATCTACAGGCATTAAAACTTTCACCCGAAGGCATATCCGGTATTAGCAGTCATTTCTAACTGTTGTCCCGAACCTATAGGTAGATTCTTACGcgTtACtcACCCGTCCGanga
>Pyhrabruck3
ctctgantGTcaGTanTAGCCcAGTAGAGTGCCTTCGCCATCGGTGTTCTTTCCAATATCTACGCATTTCACCGCTCCACTGGAAATTCCCTCTACCCCTACTATACTCAAGTTTCCCAGTTTCCAATGCTGAATTGAGGTTGAGCCTCAAGGTTTAACAGTGGACTTAAGAAACCACCTGCAGACGCTTTACGCCCAGTAATTCCGGATAACACTTGCATCCTCCGTCTTACCGCGGCTGCTGGCACGGAGTTAGCCGATGCTTCGTCTCCTAAGTAACGTCAGATCTTCCTCCTTAGGTAACAGAGGTTTACAACTCAGTAAGCCTTCTTCCCTCACGCGGTATTGCTCTGTCAGGCTTTCGCCCATTGCAGAAAATTCCTCACTGCTGCCTCCCGTAGGAGTCTGGACCGTGTCTCAGTTCCAGTGTGGCTGATCGTCCTCTCAGACCAGCTACTGATCGTCGCCTTGGTAGGCCTTTACCCCACCAACTAGCTAATCAGCCGCGAGCTTCTCTTTAGGCAGATTTCTCTGTTTGACCCGAAGGCATATGGAGTTTTAGCAGGTGTTTCCCCCTGTTATCCTCCTCCTAAAGGCGAantCTCAcgcGTTACTCACCCGTCCGa
>LoipTeich2
cGtCCtnagTGtcagTTaCGGCCTAGCAGAGCGCTTtCGCCACCGGTGTTCTTCCTGATCTCTACGCATTTCACCGCTACACCAGGAATTCCCTCTGCCCCGAACGTACTCTAGCTCTGTAGTTTCCACTGCCTTTACAAGGTTGAGCCTTGCTCTTTAACAGCAGACTTACAGTGCCACCTGCGGACGCTTTACGCCCAATCATTCCGGATAACGCTTGCATCCTCCGTATTACCGCGGCTGCTGGCACGGAGTTAGCCGATGCTTATTCCTCAGGTACCTTCATTTTTTTATTCCCTGAGAAAAGAGGTTTACAACCCAAGAGCCTTCCTCCCTCACGCGGTATTGCTCCGTCAGGCTTTCGCCCATTGCGGAAAATTCCCCACTGCTGCCTCCCGTAGGAGTCTGGGCCGTGTCTCAGTCCCAGTGTGGCTGATCATCCTCTCAGACCAGCTACTGATCGTCGCCTTGGTGCGCTCTTACCACACCAACTAGCTAATCAGACGCGAGCTCATCTCTAGGCAATAAATCTTTCACCTTTCGGCACATCCGGTATTAGCCACCGTTTCCAGTGGTTGTCCCCGACCTagAGCTaaattctCnnncGTTACTCACCCGTCCGanga
>LoipTeich3
agngTcaGTTacGGCCTAGcagAGCGCTTtCGCCACCggtgTtCTTCCtgaTCTCTACGCATTTCACCGCTACACCAGGAaTTCCCTCTGCCCCGAACGTACTCTAGCTCTGTAGTTTCCACTGCCTTTACAAGGTTGAGCCTTGCTCTTTAACAGCAGACTTACAGTGCCACCTGCGGACGCTTTACGCCCAATCATTCCGGATAACGCTTGCATCCTCCGTATTACCGCGGCTGCTGGCACGGAGTTAGCCGATGCTTATTCCTCAGGTACCTTCATTTTTTTATTCCCTGAGAAAAGAGGTTTACAACCCAAGAGCCTTCCTCCCTCACGCGGTATTGCTCCGTCAGGCTTTCGCCCATTGCGGAAAATTCCCCACTGCTGCCTCCCGTAGGAGTCTGGGCCGTGTCTCAGTCCCAGTGTGGCTGATCATCCTCTCAGACCAGCTACTGATCGTCGCCTTGGTGCGCTCTTACCACACCAACTAGCTAATCAGACGCGAGCTCATCTCTAGGCAATAAATCTTTCACCTTTCGGCACATCCGGTATTAGCCACCGTTTCCAGTGGTTGTCCCCGACCTAGAGCTaanTTCTCangCGTTacccaCCCGTCcggAGa
>LoipTeich5
CntCCtnagcGtcagTTGTGGCCcagtAGAGCGCCTTCGCCACTggtgTTCTTCCCGATATCTACGCATTTCACCGCTACACCGGGAATTCCCTCTACCCCTACCACACTCTAGTCAACCAGTTTCCATTGCCGATCCACAGTTGAGCTGTGACCTTTGACAACAGACTTAATTAACCGCCTGCGGACGCTTTACGCCCAATAATTCCGGATAACGCTTGCCTCCTCCGTCTTACCGCGGCTGCTGGCACGGAGTTAGCCGAGGCTTATTCCTCAGGTACCGTCAGTTCTTCTTCCCTGAGAAAAGAGGTTTACAACCCTAAGGCCTTCCTCCCTCACGCGGCGTTGCTCCGTCAGGCTTGCGCCCATTGCGGAAAATTCCCCACTGCTGCCTCCCGTAGGAGTCTGGGCCGTGTCTCAGTCCCAGTGTGGCTGATCATCCTCTTAGACCAGCTACTGATCGTCGCCTTGGTAAGCTCTTACCCCACCAACTAGCTAATCAGACGCGAGTTCATCCTCAGGCGATATAACATTTCACCTCTCGGCATATGGGGTATTAGCAGTCGTTTCCAACTGTTGTCCCCCTCCTAAGGGCAGATCCTCACGCgTtACTCACCCGTCCGAnga
>LoipTeich6
agTGtnagTTaCGGCCTAGCAGAGCGCTTtCGCCACCGGTGTTCTTCCTGATCTCTACGCATTTCACCGCTACACCAGGAATTCCCTCTGCCCCGAACGTACTCTAGCTCTGTAGTTTCCACTGCCTTTACAAGGTTGAGCCTTGCTCTTTAACAGCAGACTTACAGTGCCACCTGCGGACGCTTTACGCCCAATCATTCCGGATAACGCTTGCATCCTCCGTATTACCGCGGCTGCTGGCACGGAGTTAGCCGATGCTTATTCCTCAGGTACCTTCATTTTTTTATTCCCTGAGAAAAGAGGTTTACAACCCAAGAGCCTTCCTCCCTCACGCGGTATTGCTCCGTCAGGCTTTCGCCCATTGCGGAAAATTCCCCACTGCTGCCTCCCGTAGGAGTCTGGGCCGTGTCTCAGTCCCAGTGTGGCTGATCATCCTCTCAGACCAGCTACTGATCGTCGCCTTGGTGCGCTCTTACCACACCAACTAGCTAATCAGACGCGAGCTCATCTCTAGGCAATAAATCTTTCACCTTTCGGCACATCCGGTATTAGCCACCGTTTCCAGTGGTTGTCCCCGACCTaanGCTAGATTCtCACGCGTTaccanCCCGTCCGa
>LoipTeich7
agngTcaGTTacGGCCTAGCagaGCGCTTtCGCCACCggtgTtCTTCCTGATCTCTACGCATTTCACCGCTACACCAGGAaTTCCCTCTGCCCCGAACGTACTCTAGCTCTGTAGTTTCCACTGCCTTTACAAGGTTGAGCCTTGCTCTTTAACAGCAGACTTACAGTGCCACCTGCGGACGCTTTACGCCCAATCATTCCGGATAACGCTTGCATCCTCCGTATTACCGCGGCTGCTGGCACGGAGTTAGCCGATGCTTATTCCTCAGGTACCTTCATTTTTTTATTCCCTGAGAAAAGAGGTTTACAACCCAAGAGCCTTCCTCCCTCACGCGGTATTGCTCCGTCAGGCTTTCGCCCATTGCGGAAAATTCCCCACTGCTGCCTCCCGTAGGAGTCTGGGCCGTGTCTCAGTCCCAGTGTGGCTGATCATCCTCTCAGACCAGCTACTGATCGTCGCCTTGGTGCGCTCTTACCACACCAACTAGCTAATCAGACGCGAGCTCATCTCTAGGCAATAAATCTTTCACCTTTCGGCACATCCGGTATTAGCCACCGTTTCCAGTGGTTGTCCCCGACCTAGAGCTaanTTCTCACGCGTTACTCCACCCGTCCGa
>LoipTeich8
cnGtGTcnGTTaCGGCCTAGCAGAGCGCTTtCGCCACCggtgTTCTTCCTGATCTCTACGCATTTCACCGCTACACCAGGAATTCCCTCTGCCCCGAACGTACTCTAGCTCTGTAGTTTCCACTGCCTTTACAAGGTTGAGCCTTGCTCTTTAACAGCAGACTTACAGTGCCACCTGCGGACGCTTTACGCCCAATCATTCCGGATAACGCTTGCATCCTCCGTATTACCGCGGCTGCTGGCACGGAGTTAGCCGATGCTTATTCCTCAGGTACCTTCATTTTTTTATTCCCTGAGAAAAGAGGTTTACAACCCAAGAGCCTTCCTCCCTCACGCGGTATTGCTCCGTCAGGCTTTCGCCCATTGCGGAAAATTCCCCACTGCTGCCTCCCGTAGGAGTCTGGGCCGTGTCTCAGTCCCAGTGTGGCTGATCATCCTCTCAGACCAGCTACTGATCGTCGCCTTGGTGCGCTCTTACCACACCAACTAGCTAATCAGACGCGAGCTCATCTCTAGGCAATAAATCTTTCACCTTTCGGCACATCCGGTATTAGCCACCGTTTCCAGTGGTTGTCCCCGACCTAGAGCTAGattCTCACGcnTtACtcaCCCGTCCGa
>LoipZulauf2
agcGTcaGTTGTGGCCnaGTAGAGCGCCTTCGCCACTGGTGTTCTTCCCGATATCTACGCATTTCACCGCTACACCGGGAATTCCCTCTACCCCTACCACACTCAAGTTCACCAGTTTCCATTGCCGATCCACAGTTGAGCTGTGGGCTTTGACAACAGACTTAATAAACCGCCTGCGGACGCTTTACGCCCAATAATTCCGGATAACGCTTGCCTCCTCCGTCTTACCGCGGCTGCTGGCACGGAGTTAGCCGAGGCTTATTCCTCTGGTACCGTCAGTTCTTCTTCCCAGAGAAAAGAGGTTTACAACCCTAAGGCCTTCCTCCCTCACGCGGCGTTGCTCCGTCAGGCTTGCGCCCATTGCGGAAAATTCCCCACTGCTGCCTCCCGTAGGAGTCTGGGCCGTGTCTCAGTCCCAGTGTGGCTGATCATCCTCTTAGACCAGCTACTGATCGTCGCCTTGGTAGTCCATTACACTACCAACTAGCTAATCAGACGCGAGTTCATCCTTAGGCGAAAAAACATTTCACCTCTCGGCATATGGGGCATTAGCAGTCGTTTCCAACTGTTGTTCCCCTCCTAAGGGCAGATCCTCACGCGTTacccaCCCGTCCGa
>LoipTeich1
tCCtnagTGtcagTGCAgaCCcAGTaacaCGCTTtCGCCGCTGGTGTTCTTCCCAATATCTACGCATTTCACCGCTACACTGGGAATTCCTGTTACCCCTATCGCACTCTAGTTCATCAGTTTCCACTGCCCTTATGCGGTTAAGCCGCACGCTTTGACAGCAGACTTGATAAACCACCTACGGACGCTTTACGCCCAATAATTCCGGATAACGCTTGCATCCTCCGTATTACCGCGGCTGCTGGCACGGAGTTAGCCGATGCTGATTCATCAGGTACCGTCATCGATTCTTCCCTGATAAAAGAGGTTTACAACCCAAAAGCCGTCCTCCCTCACGCGGTATTGCTCCGTCAGGCTTTCGCCCATTGCGGAAAATTCCCCACTGCTGCCTCCCGTAGGAGTCTGGACCGTGTCTCAGTTCCAGTGTGCCTGGTCATCCTCTCAGACCAAGTACAGATCGTCGCCTTGGTGTGCCGTTACCACTCCAACTAGCTAATCTGACGCGAGCCAATCTCTAGACAATTAATCTTTCACCCTAAGGCACATTCGGTATTAGCAGTCGTTTCCAACTGTTGTCCCCAATCTAAAGGCaag
>IFATeich1
tcagTGtnagTTGCGGCCTAGCAGAGCGCTTtCGCCACCGGTGTTCTTCCTGATCTCTACGCATTTCACCGCTACACCAGGAATTCCCTCTGCCCCgAaCGCacTCTAGTCTTGTAGTTTCCaCTGCCCTTATGCGGTTAAGCCGCacGCTTTAACAATAGACTTACAAAACcaCCTGCGGACGCTTTACGCCCAATCATTCCGGATAACGCTTGCATCCTCCGTATTACCGCGGCTGCTGGCACGGAGTTAGCCGATGCTTATTCCTCAGGTACCGTCATCATCTTCCCTGAGAAAAGAGGTTTACAACCCAAGAGCCTTCCTCCCTCACGCGGTATTGCTCCGTCAGGCTTTCGCCCATTGCGGAAAATTCCCcACTGCTGCCTCCCGTAGGAGTCTGGACCGTGTCTCAGTTCCAGTGTGGCTGATCATCCTCTCAGACCAGCTACTGATCGCAGCCTTGGTAGTCCATTACACCACCAACTAGCTAATCAGACGCGAGCTCATCTCTTGGCAATTAATCTTTCACCCGTAGGCACATCCGGTATTAGCAGCCGTTTCCAACTGTTGTCCCGAACCAAAAGGCAGattCTCACGCGTTACTcACCcGTCcggng
>Admont1
anttnagCGTCagTTGAgaTCCAGCAGGACGCTTtCGCCACTGgTGTTCTTCCAGATATCTACGCATTTCACCGCTACACCTGGAATTCCTCCTGCCCCTATCTCTCTCTAGTCTCACAGTTTCCATTGCCGATCCAAGGTTGAGCCTCGGGCTTTGACAACAGACTTATGAAACAGCCTACGTACGCTTTACGCCCAATAATTCCGGATAACGCTTGCATCCTCCGTCTTACCGCGGCTGCTGGCACGGAGTTAGCCGATGCTTATTCGTTAGGTACCGTCATTATCTTCCCTAACAAAAGAGGTTTACAATCCACAGACCTTCGTCCCTCACGCGGTATTGCTCCGTCAGGCTTTCGCCCATTGCGGAAAATTCCCCACTGCTGCCTCCCGTAGGAGTCTGGGCCGTGTCTCAGTCCCAGTGTGACTGGTCATCCTCTCAGACCAGTTACCGATCGTCGCCATGGTGTGCCATTACCACTCCATCTAGCTAATCGGACGCAAGCTCATCTACAGATGATAAATCTTTCACCCGAAGGCATATCCGGTATTAGCAGTCGTTTCCAACTGTTGTCCCGAGTCTGTAGGTAGannnTTAcacGTTACtcACccgTCCGag
>Admont2
gtanTTcnGCGtcagTTGagaTCcAGCAGGACGCTTtCGCCACTGGTGTTCTTCCAGATATCTACGCATTTCACCGCTACACCTGGAATTCCTCCTGCCCCTATCTCTCTCTAGCCTCACAGTTTCCATTGCCTTTCCAAGGTTGAGCCTCGGGCTTTGACAACAGACTTATGAAACAGCCTACGTACGCTTTACGCCCAATAATTCCGGATAACGCTTGCATCCTCCGTCTTACCGCGGCTGCTGGCACGGAGTTAGCCGATGCTTATTCGTTAGGTACCGTCATTATCTTCCCTAACAAAAGAGGTTTACAATCCACAGACCTTCGTCCCTCACGCGGTATTGCTCCGTCAGGCTTTCGCCCATTGCGGAAAATTCCCCACTGCTGCCTCCCGTAGGAGTCTGGGCCGTGTCTCAGTCCCAGTGTGACTGGTCATCCTCTCAGACCAGTTATCGATCGTCGCCATGGTGTGCCGTTACCACTCCATCTAGCTAATCGAACGCAAGCTCATCTACAGGCATTAAAACTTTCACCCGAAGGCATATCCGGTATTAGCAGTCATTTCTAACTGTTGTCCCGAACCTATAGGTAGATTCTTACGCGTTatcncccngtCcGg
>Greifenstein3
acTTcngCGtcagTTGAGaTCCAGCAGGACGCTTtCGCCACTggtGTTCTTCCAGATATCTACGCATTTCACCGCTACACCTGGAATTCCTCCTGCCCCTATCTCTCTCTAGTCTCACAGTTTCCATTGCCGATCCAAGGTTGAGCCTCGGGCTTTGACAACAGACTTATCAAACAGCCTACGTACGCTTTACGCCCAATAATTCCGGATAACGCTTGCATCCTCCGTCTTACCGCGGCTGCTGGCACGGAGTTAGCCGATGCTTATTCGTTAGGTACCGTCATTATCTTCCCTAACAAAAGAGGTTTACAACCCACAGGCCTTCGTCCCTCACGCGGTATTGCTCCGTCAGGCTTTCGCCCATTGCGGAAAATTCCCCACTGCTGCCTCCCGTAGGAGTCTGGGCCGTGTCTCAGTCCCAGTGTGACTGGTCATCCTCTCAGACCAGTTATCGATCGTCGCCATGGTAGGCCGTTACCCCACCATCTAGCTAATCGAACGCAAGCTCATCTACAGGCATTAAAACTTTCACCCGAAGGCATATCCGGTATTAGCAGTCATTTCTAACTGTTGTCCCGAACCTATAGGTAGATTCTTACGCGTTACtcaCCCGTCCGa
>LoipQuelleF
caGTGTCaGTTGCAGCCTAGCAGGgCGCTTtCGCCACCGgtGTTCTTCCTGATCTCTACGCATTTCACCGCTACACCAGGAATTCCCCCTGCCCCGAATGCACTCTAGTTACACAGTTTCCACTGCCTTTATGCGGTTGAGCCGCACGCTTTGACAATAGACTTGCATCACCACCTACGGACGCTTTACGCCCAATCATTCCGGATAACGCTTGCATCCTCCGTATTACCGCGGCTGCTGGCACGGAGTTAGCCGATGCTTCTTCCTCAGGTACCGTCATCTCTTCTTCCCTGAGAAAAGAGGTTTACAACCCAAGAGCCTTCCTCCCTCACGCGGTATTGCTCCGTCAGGCTTTCGCCCATTGCGGAAAATTCCCCACTGCTGCCTCCCGTAGGAGTCTGGGCCGTGTCTCAGTCCCAGTGTGGCTGATCATCCTCTCAGACCAGCTACTGATCGTCGCCATGGTAGGCTCTTACCCCACCATCTAGCTAATCAGACGCGAGCTCATCTCTAGGCAGCTAGCCTTTCACCTCTTCGGCACATCCGGTATTAGCCACCGTTTCCAGTGGTTGTCCCGAACCTAGAGCCAGaTTCTCACGcgTTaccanCcccgTCCGa
>Branna1
gtGtcagTTaCGGCCTAGCAGAGCGCCTTCGCCACCggtgTTCTTCCTGATCTCTACGCATTTCACCGCTACACCAGGAATTCCCTCTGCCCCGAACGTACTCTAGCTGTGTAGTTTCCACTGCTTTTATGAGGTTAAGCCTCACTCTTTAACAGCAGACTTACATTGCCACCTGCGGACGCTTTACGCCCAATCATTCCGGATAACGCTTGCATCCTCCGTATTACCGCGGCTGCTGGCACGGAGTTAGCCGATGCTTATTCCTCAAGTACCTTCAGTTCTTATTCCTTGAGAAAAGAGGTTTACAACCCAAGAGCCTTCCTCCCTCACGCGGTATTGCTCCGTCAGGCTTTCGCCCATTGCGGAAAATTCCCCACTGCTGCCTCCCGTAGGAGTCTGGGCCGTGTCTCAGTCCCAGTGTGGCTGATCATCCTCTCAGACCAGCTACTGATCGTCGCCTAGGTGCGCTCTTACCACACCTACTAGCTAATCAGACGCGAGCTCATCTTCAGGCAGTTAACCTTTCACCTTTCGGCACATCCGGTATTAGCCACCGTTTCCAGTGGTTGTCCCCGACCTCAAGCTagatncncACGCGTTACtcaCccgtCCGnng
>Branna2
cGtCCtnagTGtcagTTaCGGCCTAGCAGAGCGCCTTCGCCACCGGTGTTCTTCCTGATCTCTACGCATTTCACCGCTACACCAGGAATTCCCTCTGCCCCGAACGTACTCTAGCTGTGTAGTTTCCACTGCTTTTATGAGGTTAAGCCTCACTCTTTAACAGCAGACTTACATTGCCACCTGCGGACGCTTTACGCCCAATCATTCCGGATAACGCTTGCATCCTCCGTATTACCGCGGCTGCTGGCACGGAGTTAGCCGATGCTTATTCCTCAAGTACCTTCAGTTCTTATTCCTTGAGAAAAGAGGTTTACAACCCAAGAGCCTTCCTCCCTCACGCGGTATTGCTCCGTCAGGCTTTCGCCCATTGCGGAAAATTCCCCACTGCTGCCTCCCGTAGGAGTCTGGGCCGTGTCTCAGTCCCAGTGTGGCTGATCATCCTCTCAGACCAGCTACTGATCGTCGCCTAGGTGCGCTCTTACCACACCTACTAGCTAATCAGACGCGAGCTCATCTTCAGGCAGTTAACCTTTCACCTTTCGGCACATCCGGTATTAGCCACCGTTTCCAGTGGTTGTCCCCGACCTCAAGCTAAatnCTCACg
>Branna8
tCctcngtGTcaGTTGCGGCCTAGCAGAGCGCTTTCGCCACCGGTGTTCTTCCTGATCTCTACGCATTTCACCGCTACACCAGGAATTCCCTCTGCCCCGAACGCACTCTAGTCTTGTAGTTTCCACTGCCCTTATGCGGTTAAGCCGCACGCTTTAACAATAGACTTACAAAACCACCTGCGGACGCTTTACGCCCAATCATTCCGGATAACGCTTGCATCCTCCGTATTACCGCGGCTGCTGGCACGGAGTTAGCCGATGCTTATTCCTCAGGTACCGTCATCATCTTCCCTGAGAAAAGAGGTTTACAACCCAAGAGCCTTCCTCCCTCACGCGGTATTGCTCCGTCAGGCTTTCGCCCATTGCGGAAAATTCCCCACTGCTGCCTCCCGTAGGAGTCTGGACCGTGTCTCAGTTCCAGTGTGGCTGATCATCCTCTCAGACCAGCTACTGATCGCAGCCTTGGTAGTCCATTACACCACCAACTAGCTAATCAGACGCGAGCTCATCTCTTGgCAATtAATCTTTCACCCGTAgGCACATCCGGTATTAncAGCCGTTTCCAACTGntGTCCCGAAcCAaAAAg
>Branna9
caGTGTcnGTTaCGGCCTAGCAGAGCGCCTTCGCCACCGgtGTTCTTCCTGATCTCTACGCATTTCACCGCTACACCAGGAATTCCCTCTGCCCCGAACGTACTCTAGCTGTGTAGTTTCCACTGCTTTTATGAGGTTAAGCCTCACTCTTTAACAGCAGACTTACATTGCCACCTGCGGACGCTTTACGCCCAATCATTCCGGATAACGCTTGCATCCTCCGTATTACCGCGGCTGCTGGCACGGAGTTAGCCGATGCTTATTCCTCAAGTACCTTCAGTTCTTATTCCTTGAGAAAAGAGGTTTACAACCCAAGAGCCTTCCTCCCTCACGCGGTATTGCTCCGTCAGGCTTTCGCCCATTGCGGAAAATTCCCCACTGCTGCCTCCCGTAGGAGTCTGGGCCGTGTCTCAGTCCCAGTGTGGCTGATCATCCTCTCAGACCAGCTACTGATCGTCGCCTAGGTGCGCTCTTACCACACCTACTAGCTAATCAGACGCGAGCTCATCTTCAGGCAGTTAACCTTTCACCTTTCGGCACATCCGGTATTAGCCACCGTTTCCAGTGGTTGTCCCCGACCTCAAGCTaaatnCtanCGCGTTACTcACCCGTCcgg
>Steg3
tCnTGagCGTcaGTtaTGGCCcaGCaaGAGCGCCTTCGCCACTGGTGTTCTTCCCGATATCTACGCATTTCACCGCTACACCGGGAATTCCCTCTGCCCCTACCACACTCAAGCCTTGTAGTTTCCATCGCTCAAATGGAGTTAAGCTCCACGCTTTAACGACAGACTTACAAGGCCGCCTGCGGACGCTTTACGCCCAATAATTCCGGATAACGCTTGCCACTCCCGTATTACCGCGGCTGCTGGCACGGAATTAGCCGTGGCTTATTCCTCAAGTACCGTCATGTCTTCTTCCTTGAGAAAAGAGGTTTACAGCCCAGAGGCCTTCATCCCTCACGCGGCGTTGCTCCGTCAGGCTTTCGCCCATTGCGGAAAATTCCCCACTGCTGCCTCCCGTAGGAGTCTGGGCCGTGTCTCAGTCCCAGTGTGGCTGATCATCCTCTCAGACCAGCTACTGATCGTCGCCTTGGTGGGCCATTACCCCACCAACTAGCTAATCAGACGCGGGCTCATCCTCAGGCGAAATTCATTTCACCTCTCGGCATATGGGGTATTAGCGGCCGTTTCCGGCCGTTATCCCCCTCCTGAGGGCagATTCCCACGCGTTACtcaCCCGTCcgga